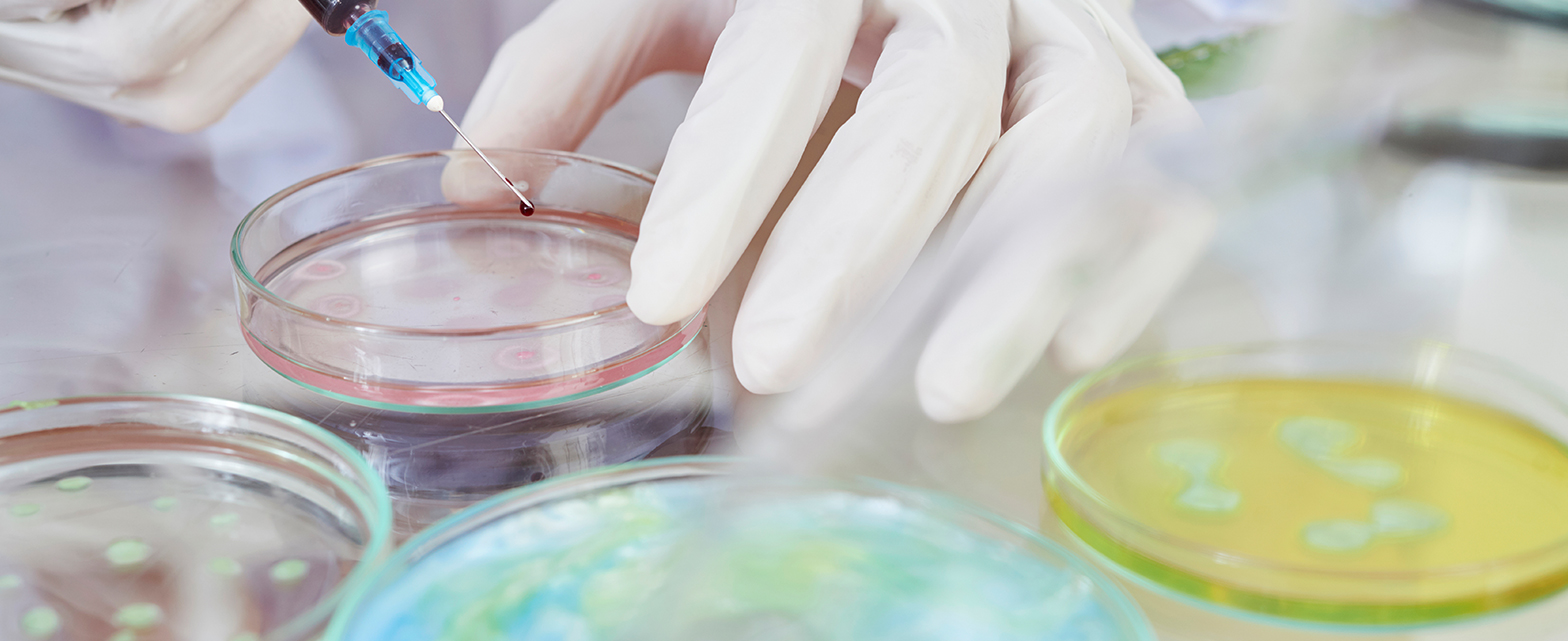

發布時間:2023-07-28 來源:
摘要:本文參照2020版《中國藥典》,采用全多孔色譜柱Alphasil VC-C18,對黃芩供試品進行分析,結果顯示,黃芩中目標峰峰形良好,黃芩苷目標峰理論塔板數大于2500,符合《中國藥典》要求。本方案可為黃芩中黃芩苷的測定提供參考。
關鍵詞:黃芩 黃芩苷 HPLC Alphasil VC-C18
實驗條件及結果
供試品溶液的制備
取本品中粉約0.3 g,精密稱定,加70%乙醇40 mL,加熱回流3小時,放冷,濾過,濾液置100 mL量瓶中,用少量70%乙醇分次洗滌容器和殘渣,洗液濾入同一量瓶中,加70%乙醇至刻度,搖勻。精密量取1 mL,置10 mL量瓶中,加甲醇至刻度,搖勻,即得。
色譜條件
儀 器:華譜S6000高效液相色譜儀
色 譜 柱:Alphasil VC-C18(4.6×250 mm,5 μm)
流 動 相:甲醇:水:磷酸=47:53:0.2
柱 溫:30 ℃
檢測波長:280 nm
流 速:1.0 mL/min
進 樣 量:10 μL
實驗結果
|
|
|
序號 |
名稱 |
保留時間(min) |
USP拖尾 |
USP分離度 |
理論塔板數 |
|
1 |
黃芩苷 |
15.566 |
1.08 |
2.44 |
9342 |
結論
本文參照2020版《中國藥典》,采用全多孔色譜柱Alphasil VC-C18,對黃芩供試品進行分析,結果顯示,黃芩中目標峰峰形良好,黃芩苷目標峰理論塔板數大于2500,符合《中國藥典》要求。本方案可為黃芩中黃芩苷的測定提供參考。
感謝您對華譜產品的關注與信任,如您在瀏覽網站期間有任何疑問或產品有任何異常情況,請留言給我們或致電我司。
客戶服務熱線 :400-108-7908,
我們將第一時間與您取得聯系,祝您和家人幸福安康!